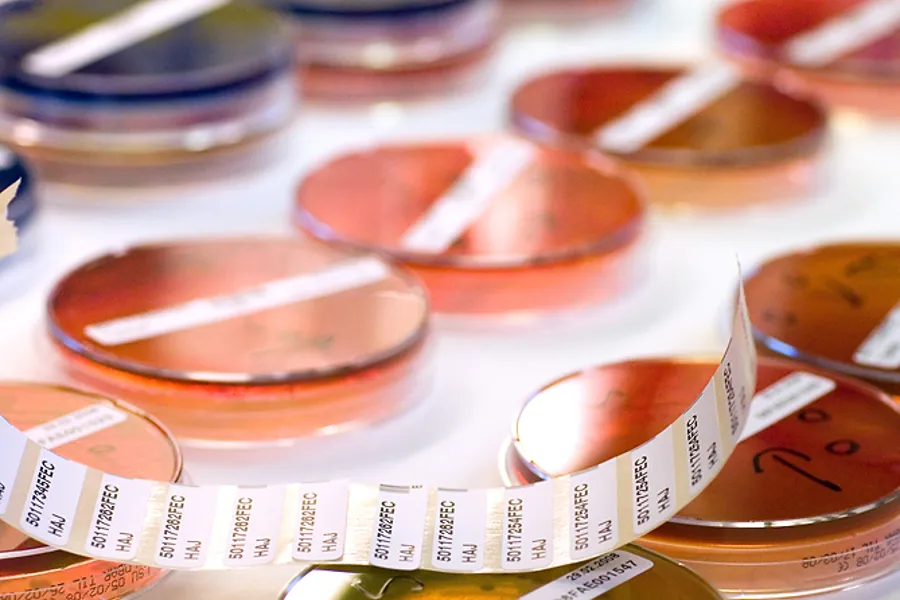

Epivakt - Varsel om utbrudd i sykehus
Tenk å oppdage et utbrudd av smittsom sykdom på sykehus så tidlig som mulig, før det blir stort og krevende?
Foto: Colourbox
Utbrudd av smittsom sykdom i sykehus er en alvorlig trussel mot pasientsikkerheten. Avansert behandling som intensiv behandling, protesekirurgi, transplantasjoner og nyfødtmedisiner bare mulig så lenge infeksjoner kan kontrolleres.
Utbrudd har store konsekvenser for ansatte og pasienter som berøres.
Automatisk overvåkning
I dag blir utbrudd oppdaget fordi helsearbeidere i klinikken eller på mikrobiologisk avdeling reagerer på opphoping av tilfeller. Da er ofte utbruddet godt i gang.
Dette vil regional smittevernoverlege Anne Mette Asfeldt og kolleger ved de mikrobiologiske laboratoriene i UNN og NLSH samt Helse Nord IKT gjøre noe med.
Gjennom tildeling av innovasjonsmidler fra Helse Nord RHF skal prosjektgruppa implementere en automatisert overvåkning av mikrobiologiske funn i Helse Nord. Overvåkingen vil varsle dersom det er flere funn av en enkelt mikrobe enn det som er vanlig, og et slikt varsel vil bli undersøkt nærmere for å finne ut om det skyldes et utbrudd.
Med Epivakt vil Helse Nord få på plass en manglende brikke i infeksjonsovervåkningen som gir mulighet til å forhindre større utbrudd.